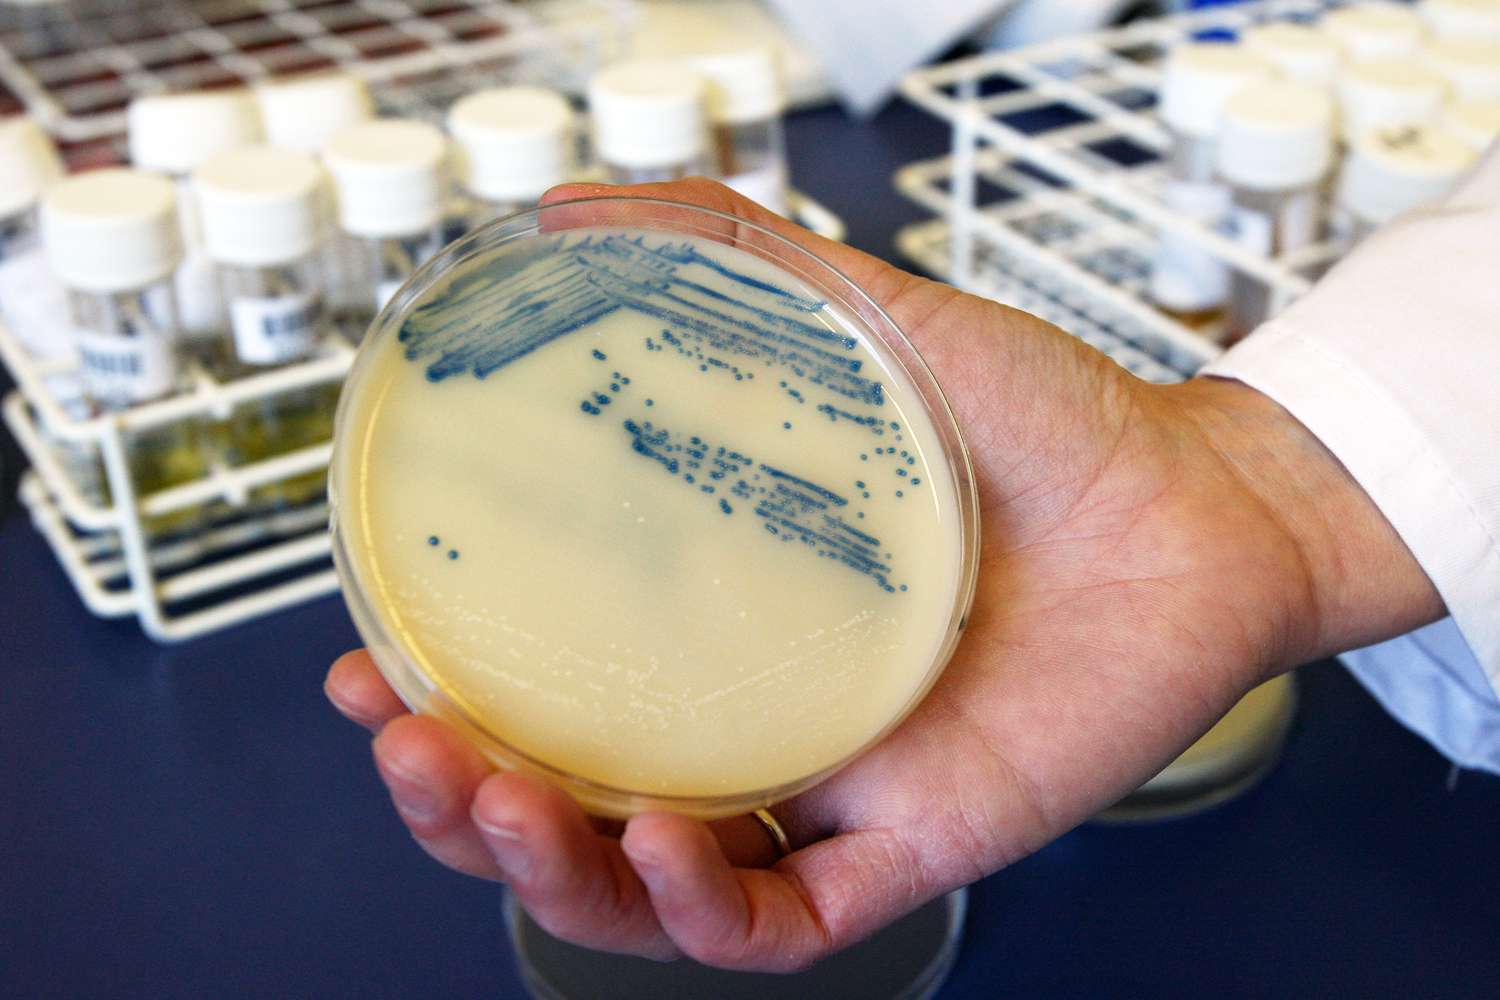
Deadly Drug-Resistant Fungus Is Sweeping Through Hospitals

NEED TO KNOW
C. auris — a deadly and drug-resistant fungus — is rapidly spreading in hospitalsHealth officials call for urgent action to prevent further spread on a global scaleIn 2023, the fungus was found in 18 countries, and more than 10,000 clinical cases have been confirmed in the United States over the past decade
Candidozyma auris (formerly known as Candida auris), a drug-resistant fungus that can cause death and serious illnesses in people with weakened immune systems, is spreading “rapidly.”
On Thursday, Sept. 11, the European Center for Disease Control and Prevention (ECDC) confirmed that the fungus, which typically spreads within healthcare facilities, is hitting European hospitals and posing a serious threat.
“Case numbers are rising, outbreaks are growing in scale, and several countries report ongoing local transmission,” the agency said in a release.
The ECDC reported that five countries – Spain, Greece, Italy, Romania, and Germany – have accounted for the majority of cases over the past decade. In 2023, the fungus was found in 18 countries, and with the latest reports, the health agency calls for urgent action to prevent global spread.
“C. auris has spread within only a few years – from isolated cases to becoming widespread in some countries,” said Dr. Diamantis Plachouras, head of the ECDC’s Antimicrobial Resistance and Healthcare-Associated Infections section. “This shows how rapidly it can establish itself in hospitals. But this is not inevitable. Early detection and rapid, coordinated infection control can still prevent further transmission.”
Candida auris.
BSIP/Education Images/Universal Images Group via Getty
Never miss a story — sign up for PEOPLE’s free daily newsletter to stay up-to-date on the best of what PEOPLE has to offer, from celebrity news to compelling human interest stories.
According to the CDC, there were 10,788 clinical cases in the United States from 2016-2023, with the majority of cases occurring in New York, Florida, California, Nevada and Illinois.
The first reported case of C. auris occurred in the United States in 2013, when a 61-year-old woman with respiratory failure came to New York from the United Arab Emirates, according to The New York Times. She died a week later.
Early identification is critical when dealing with C. auris, although treating the fungus can be difficult, as over 90 percent of C. auris infections are resistant to at least one type of drug, according to the CDC.
C. auris infections have been “found in patients of all ages, from preterm infants to the elderly,” the CDC says, adding that “patients who have been hospitalized in a healthcare facility a long time, and and have lines and tubes that go into their body (such as breathing tubes, feeding tubes and central venous catheters), seem to be at highest risk.”